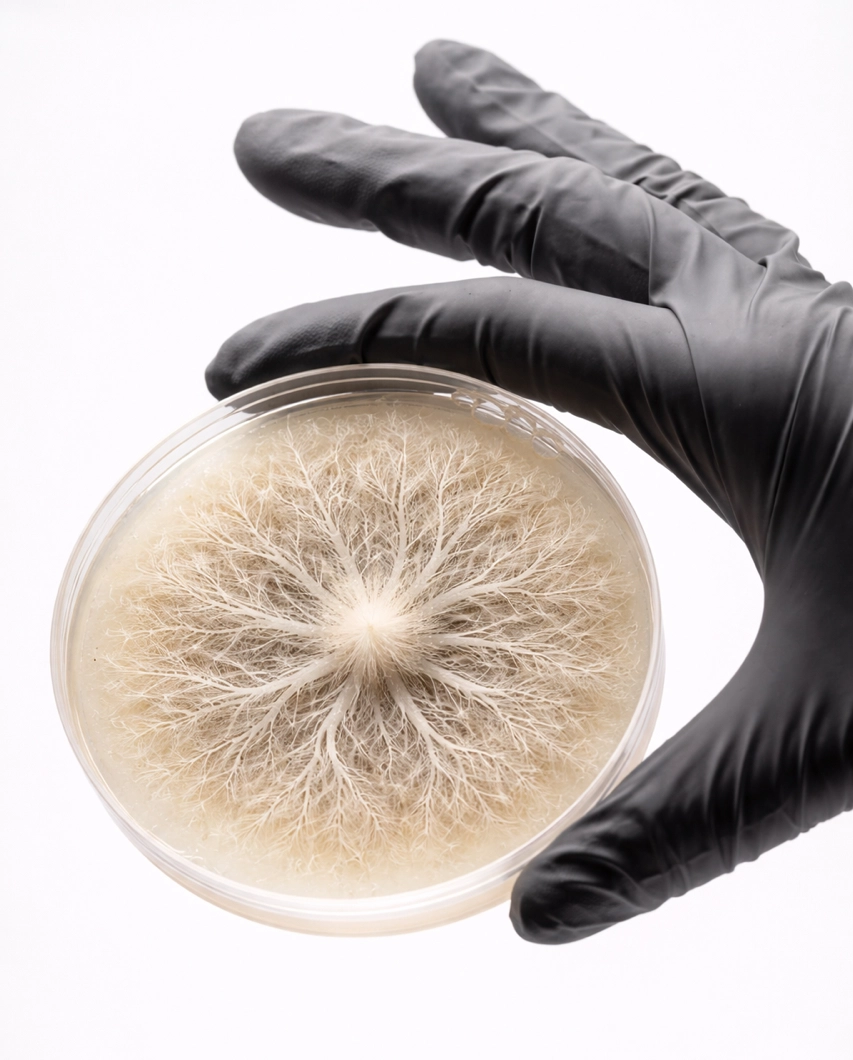
2039-9a7cc637-2e5d-4026-a26b-aa5e2de34a52png-17750502130132.png

A Biomaterial Technology Company
What we do?
At MYCOTEX we engineer next-generation mycelium-based biomaterials for real world product applications.
Develop biomaterials created from mycelium (natural, regenerative, biodegradable).
Customizable by application in texture, thickness, and form.
Produced through automated, waste-free processes.
Scaled through third-party manufacturing.

Applications
Cover – PARYCEL© can be seamlessly sprayed onto interior natural material surfaces as a cover.
Construct – KYTARIN© can be 3D molded into innovative textures, reliefs, and shapes as a component or construction material for furniture and interiors.
R&D - Our R&D services empowers companies to create new innovative sustainable materials and binders from our base material technology.

Why it maters?
Eliminates material waste.
Reduces overproduction and pollution.
Uses natural, renewable resources.
Regenerative can be broken down and reused.
Biodegradable and able to return safely to the environment.

How it works
Mycelium based biomaterials engineered for the next generation of products.
MYCOTEX enables companies to work with biomaterials that are not only sustainable, but fundamentally different.
Engineered instead of grown.
Circular by design.



